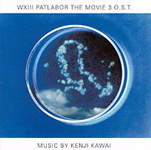

Atomic Atonality 2
Atomic Atonality 2
First broadcast on Resonance-FM, London - Tuesday 18th March 2014
1. 2.
2. 3.
3. 4.
4. 5.
5.
6. 7.
7. 8.
8. 9.
9. 10.
10.
11. 12.
12. 13.
13. 14.
14. 15.
15.
16. 17.
17. 18.
18.
1. Angelo Badalamenti - "Blue Velvet" -
from the film Blue Velvet (1986), dir"ected by David Lynch
2. Angelo Badalamenti - "Regan’s Theme (finale) -
from the film (1986), directed by David Lynch
3. Bernard Herrmann - "Opening Credits" -
from the film Taxi Driver (1976), directed by Martin Scorsese
4. Bernard Herrmann - "Shoot-out Aftermath" -
from the film Taxi Driver (1976), directed by Martin Scorsese
5. Herbie Hancock - "Suite Revenge" -
from the film Death Wish (1974), directed by Michael Winner
6. Lesiman - "Moto Centripedo" -
from the LP Here And Now (1973)
7. Mike Curb & Lawrence Brown - "Grass Party" -
from the film Mary Jane (1967), directed by Maury Dexter
8. Terence Blanchard - "Frazier’s Tour" -
from the film Inside Man (2006), directed by Spike Lee
9. Aaron Copeland - "NewYork Profile" -
from the film Something Wild (1961), directed by Jack Garfein
10. Howard Shore - "Yellow Betray Blue" -
from the film Cop Land (1997), directed by James Mangold
11. Howard Shore - "The Diagonal Rule" -
from the film Cop Land (1997), directed by James Mangold
12. Philip Glass - "Caravan Moves Out" -
from the film Kundum (1997), directed by Martin Scorsese
13. James Wong - "Once Upon A Time In China" -
from the film Once Upon A Time In China (1991), directed by Hark Tsui
14. Tan Dun - "Night Fight" -
from the film Crouching Tiger Hidden Dragon (2000), directed by Ang Lee
15. Kenji Kawai - "Murphy’s Ghost" -
from the film Avalon (2001), directed by Mamoru Oshii
16. Kenji Kawai - "Ending" -
from the film Wasted XIX: Patlabor The Movie 3 (2002), directed by Takuji Endo & Fumihiko Takayama
17. Ennio Morricone - "Theme of Memories" -
from the film The Iron Mayor (1977), directed by Pasquale Squitieri
18. Ennio Morricone - "Terrorists!" -
from the film The Human Factor (1975), directed by Edward Dmytryk
